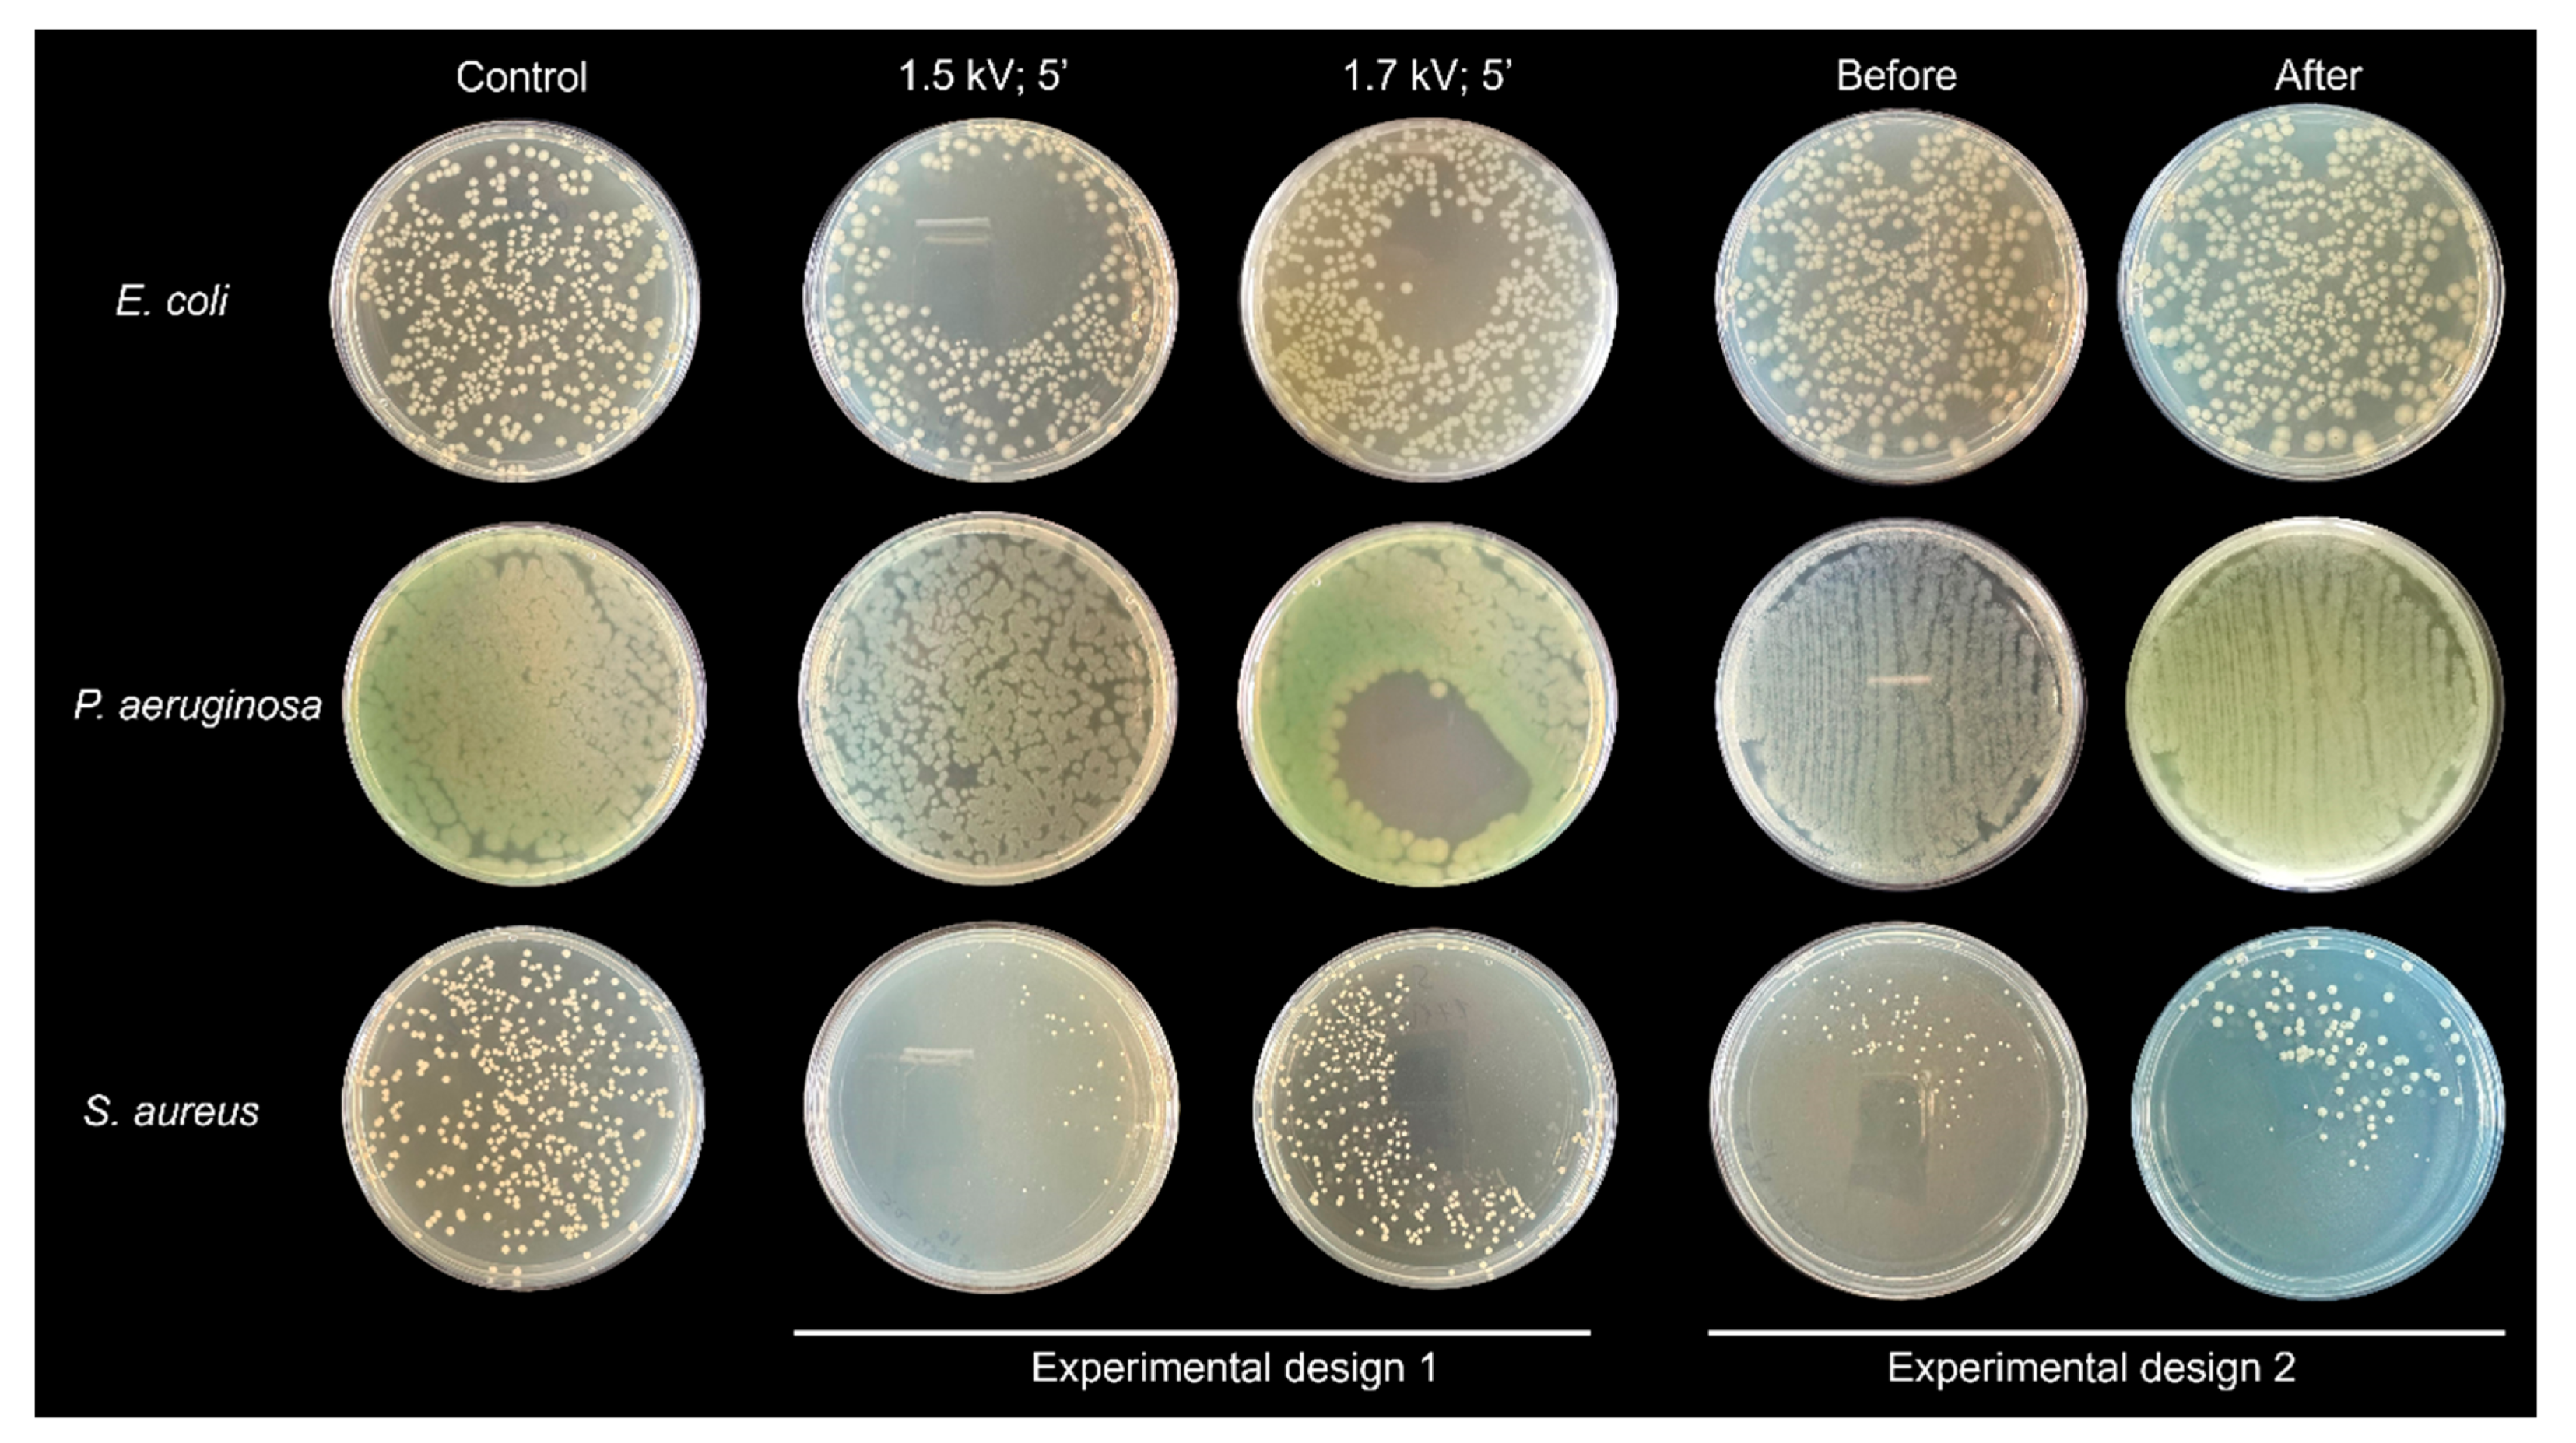
Applsci 15 02527 g005

Biological Decontamination by Microplasma
Abstract
1. Introduction
2. Materials and Methods
2.1. Experimental Setup
2.2. Microplasma Electrode
2.3. Ozone Generation
2.4. Microbiology Assay
2.5. Statistical Analyses
3. Results
4. Discussions
5. Conclusions
Author Contributions
Funding
Institutional Review Board Statement
Informed Consent Statement
Data Availability Statement
Conflicts of Interest
References
- Shimizu, K.; Yamada, M.; Kanamori, M.; Blajan, M. Basic study of bacteria inactivation at low discharge voltage by using microplasmas. IEEE Trans. Ind. Appl. 2010, 46, 641–649. [Google Scholar] [CrossRef]
 - Shimizu, K.; Kristof, J.; Blajan, M.G. Applications of Dielectric Barrier Discharge Microplasma; IntechOpen eBooks: London, UK, 2019. [Google Scholar] [CrossRef]
 - Li, H.; Kang, Z.; Jiang, E.; Song, R.; Zhang, Y.; Qu, G.; Wang, T.; Jia, H.; Zhu, L. Plasma induced efficient removal of antibiotic-resistant Escherichia coli and antibiotic resistance genes, and inhibition of gene transfer by conjugation. J. Hazard. Mater. 2021, 419, 126465. [Google Scholar] [CrossRef] [PubMed]
 - Zhang, A.; Jiang, X.; Ding, Y.; Jiang, N.; Ping, Q.; Wang, L.; Liu, Y. Simultaneous removal of antibiotics and antibiotic resistance genes in wastewater by a novel nonthermal plasma/peracetic acid combination system: Synergistic performance and mechanism. J. Hazard. Mater. 2023, 452, 131357. [Google Scholar] [CrossRef] [PubMed]
 - Li, H.; Zhang, R.; Zhang, J.; Wang, Q.; Wang, Y.; Zhou, J.; Wang, T. Conjugation transfer of plasma-induced sublethal antibiotic resistance genes under photoreactivation: Alleviation mechanism of intercellular contact. J. Hazard. Mater. 2023, 455, 131620. [Google Scholar] [CrossRef]
 - Ehlbeck, J.; Schnabel, U.; Polak, M.; Winter, J.; Von Woedtke, T.; Brandenburg, R.; Von Dem Hagen, T.; Weltmann, K. Low temperature atmospheric pressure plasma sources for microbial decontamination. J. Phys. D Appl. Phys. 2010, 44, 013002. [Google Scholar] [CrossRef]
 - Weltmann, K.-D.; Polak, M.; Masur, K.; Von Woedtke, T.; Winter, J.; Reuter, S. Plasma processes and plasma sources in medicine. Contrib. Plasma Phys. 2012, 52, 644–654. [Google Scholar] [CrossRef]
 - Weltmann, K.-D.; Kindel, E.; Von Woedtke, T.; Hähnel, M.; Stieber, M.; Brandenburg, R. Atmospheric-pressure plasma sources: Prospective tools for plasma medicine. Pure Appl. Chem. 2010, 82, 1223–1237. [Google Scholar] [CrossRef]
 - Zhu, T.; Fu, S.; Xie, W.; Li, F.; Liu, Y. Comparison of inactivation characteristics of Escherichia coli and Staphylococcus aureus in water by rotary plasma jet sterilization. Environ. Technol. Innov. 2024, 36, 103746. [Google Scholar] [CrossRef]
 - Juozaitienė, V.; Jonikė, V.; Mardosaitė-Busaitienė, D.; Griciuvienė, L.; Kaminskienė, E.; Radzijevskaja, J.; Venskutonis, V.; Riškevičius, V.; Paulauskas, A. Application of cold plasma therapy for managing subclinical mastitis in cows induced by Streptococcus agalactiae, Streptococcus uberis and Escherichia coli. Vet. Anim. Sci. 2024, 25, 100378. [Google Scholar] [CrossRef]
 - Wang, Q.; Lavoine, N.; Salvi, D. Cold atmospheric pressure plasma for the sanitation of conveyor belt materials: Decontamination efficacy against adherent bacteria and biofilms of Escherichia coli and effect on surface properties. Innov. Food Sci. Emerg. Technol. 2022, 84, 103260. [Google Scholar] [CrossRef]
 - Gershman, S.; Harreguy, M.B.; Yatom, S.; Raitses, Y.; Efthimion, P.; Haspel, G. A low power flexible dielectric barrier discharge disinfects surfaces and improves the action of hydrogen peroxide. Sci. Rep. 2021, 11, 4626. [Google Scholar] [CrossRef] [PubMed]
 - Mosaka, T.B.M.; Unuofin, J.O.; Daramola, M.O.; Tizaoui, C.; Iwarere, S.A. Rapid susceptibility of Carbapenem resistant Pseudomonas aeruginosa and its resistance gene to non-thermal plasma treatment in a batch reactor. J. Water Process Eng. 2024, 65, 105915. [Google Scholar] [CrossRef]
 - Zhao, Y.; Shao, L.; Duan, M.; Liu, Y.; Sun, Y.; Zou, B.; Wang, H.; Dai, R.; Li, X.; Jia, F. TMT-based quantitative proteomics and non-targeted metabolomic analyses reveal the inactivation mechanism of cold atmospheric plasma against Pseudomonas aeruginosa. Food Control 2024, 165, 110608. [Google Scholar] [CrossRef]
 - Zhao, Y.; Shao, L.; Jia, L.; Zou, B.; Dai, R.; Li, X.; Jia, F. Inactivation effects, kinetics and mechanisms of air- and nitrogen-based cold atmospheric plasma on Pseudomonas aeruginosa. Innov. Food Sci. Emerg. Technol. 2022, 79, 103051. [Google Scholar] [CrossRef]
 - Blajan, M.G.; Yahaya, A.G.; Kristof, J.; Okuyama, T.; Shimizu, K. Inactivation of Staphylococcus aureus by microplasma. IEEE Trans. Ind. Appl. 2022, 59, 434–440. [Google Scholar] [CrossRef]
 - Liao, X.; Xiang, Q.; Liu, D.; Chen, S.; Ye, X.; Ding, T. Lethal and Sublethal Effect of a Dielectric Barrier Discharge Atmospheric Cold Plasma on Staphylococcus aureus. J. Food Prot. 2017, 80, 928–932. [Google Scholar] [CrossRef]
 - Choi, M.-S.; Jeon, E.B.; Kim, J.Y.; Choi, E.H.; Lim, J.S.; Choi, J.; Park, S.Y. Impact of non-thermal dielectric barrier discharge plasma on Staphylococcus aureus and Bacillus cereus and quality of dried blackmouth angler (Lophiomus setigerus). J. Food Eng. 2020, 278, 109952. [Google Scholar] [CrossRef]
 - Liu, X.; Hong, F.; Guo, Y.; Zhang, J.; Shi, J. Sterilization of Staphylococcus aureus by an atmospheric Non-Thermal plasma jet. Plasma Sci. Technol. 2013, 15, 439–442. [Google Scholar] [CrossRef]
 - Cotter, J.J.; Maguire, P.; Soberon, F.; Daniels, S.; O’Gara, J.P.; Casey, E. Disinfection of meticillin-resistant Staphylococcus aureus and Staphylococcus epidermidis biofilms using a remote non-thermal gas plasma. J. Hosp. Infect. 2011, 78, 204–207. [Google Scholar] [CrossRef]
 - Tian, Y.; Sun, P.; Wu, H.; Bai, N.; Wang, R.; Zhu, W.; Zhang, J.; Liu, F. Inactivation of Staphylococcus aureus and Enterococcus faecalis by a direct-current, cold atmospheric-pressure air plasma microjet. J. Biomed. Res. 2010, 24, 264–269. [Google Scholar] [CrossRef]
 - Yoo, J.H.; Baek, K.H.; Heo, Y.S.; Yong, H.I.; Jo, C. Synergistic bactericidal effect of clove oil and encapsulated atmospheric pressure plasma against Escherichia coli O157:H7 and Staphylococcus aureus and its mechanism of action. Food Microbiol. 2020, 93, 103611. [Google Scholar] [CrossRef] [PubMed]
 - Korachi, M.; Gurol, C.; Aslan, N. Atmospheric plasma discharge sterilization effects on whole cell fatty acid profiles of Escherichia coli and Staphylococcus aureus. J. Electrost. 2010, 68, 508–512. [Google Scholar] [CrossRef]
 - Ji, S.H.; Ki, S.H.; Ahn, J.H.; Shin, J.H.; Hong, E.J.; Kim, Y.J.; Choi, E.H. Inactivation of Escherichia coli and Staphylococcus aureus on contaminated perilla leaves by Dielectric Barrier Discharge (DBD) plasma treatment. Arch. Biochem. Biophys. 2018, 643, 32–41. [Google Scholar] [CrossRef]
 - Han, L.; Patil, S.; Boehm, D.; Milosavljević, V.; Cullen, P.J.; Bourke, P. Mechanisms of Inactivation by High-Voltage Atmospheric Cold Plasma Differ for Escherichia coli and Staphylococcus aureus. Appl. Environ. Microbiol. 2015, 82, 450–458. [Google Scholar] [CrossRef]
 - Kondeti, V.S.S.K.; Phan, C.Q.; Wende, K.; Jablonowski, H.; Gangal, U.; Granick, J.L.; Hunter, R.C.; Bruggeman, P.J. Long-lived and short-lived reactive species produced by a cold atmospheric pressure plasma jet for the inactivation of Pseudomonas aeruginosa and Staphylococcus aureus. Free Radic. Biol. Med. 2018, 124, 275–287. [Google Scholar] [CrossRef]
 - Bayliss, D.L.; Shama, G.; Kong, M.G. Restoration of antibiotic sensitivity in meticillin-resistant Staphylococcus aureus following treatment with a non-thermal atmospheric gas plasma. Int. J. Antimicrob. Agents 2013, 41, 398–399. [Google Scholar] [CrossRef]
 - Huang, M.; Zhuang, H.; Zhao, J.; Wang, J.; Yan, W.; Zhang, J. Differences in cellular damage induced by dielectric barrier discharge plasma between Salmonella Typhimurium and Staphylococcus aureus. Bioelectrochemistry 2019, 132, 107445. [Google Scholar] [CrossRef]
 - Joshi, S.G.; Paff, M.; Friedman, G.; Fridman, G.; Fridman, A.; Brooks, A.D. Control of methicillin-resistant Staphylococcus aureus in planktonic form and biofilms: A biocidal efficacy study of nonthermal dielectric-barrier discharge plasma. Am. J. Infect. Control 2010, 38, 293–301. [Google Scholar] [CrossRef]
 - Liao, X.; Li, J.; Suo, Y.; Ahn, J.; Liu, D.; Chen, S.; Hu, Y.; Ye, X.; Ding, T. Effect of preliminary stresses on the resistance of Escherichia coli and Staphylococcus aureus toward non-thermal plasma (NTP) challenge. Food Res. Int. 2017, 105, 178–183. [Google Scholar] [CrossRef]
 - Gök, V.; Aktop, S.; Özkan, M.; Tomar, O. The effects of atmospheric cold plasma on inactivation of Listeria monocytogenes and Staphylococcus aureus and some quality characteristics of pastırma—A dry-cured beef product. Innov. Food Sci. Emerg. Technol. 2019, 56, 102188. [Google Scholar] [CrossRef]
 - Burts, M.L.; Alexeff, I.; Meek, E.T.; McCullers, J.A. Use of atmospheric non-thermal plasma as a disinfectant for objects contaminated with methicillin-resistant Staphylococcus aureus. Am. J. Infect. Control 2009, 37, 729–733. [Google Scholar] [CrossRef] [PubMed]
 - Iza, F.; Kim, G.J.; Lee, S.M.; Lee, J.K.; Walsh, J.L.; Zhang, Y.T.; Kong, M.G. Microplasmas: Sources, particle kinetics, and biomedical applications. Plasma Process. Polym. 2008, 5, 322–344. [Google Scholar] [CrossRef]
 - Heeren, T.; Ueno, T.; Wang, N.D.; Namihira, T.; Katsuki, S.; Akiyama, H. Novel dual Marx Generator for microplasma applications. IEEE Trans. Plasma Sci. 2005, 33, 1205–1209. [Google Scholar] [CrossRef]
 - Rusterholtz, D.L.; Lacoste, D.A.; Stancu, G.D.; Pai, D.Z.; Laux, C.O. Ultrafast heating and oxygen dissociation in atmospheric pressure air by nanosecond repetitively pulsed discharges. J. Phys. D Appl. Phys. 2013, 46, 464010. [Google Scholar] [CrossRef]
 - Zhang, L.; Wang, K.; Wu, K.; Guo, Y.; Liu, Z.; Yang, D.; Zhang, W.; Luo, H.; Fu, Y. Air disinfection by nanosecond pulsed DBD plasma. J. Hazard. Mater. 2024, 472, 134487. [Google Scholar] [CrossRef]
 - European Committee on Antimicrobial Susceptibility Testing. 2020. Available online: http://www.eucast.org (accessed on 1 October 2024).
 - Leclercq, R.; Canton, R.; Brown, D.F.J.; Giske, C.G.; Heisig, P.; MacGowan, A.P.; Kahlmeter, G. EUCAST expert rules in antimicrobial susceptibility testing. Clin. Microbiol. Infect. 2013, 19, 141–160. [Google Scholar] [CrossRef]
 - Matuschek, E.; Brown, D.F.J.; Kahlmeter, G. Development of the EUCAST disk diffusion antimicrobial susceptibility testing method and its implementation in routine microbiology laboratories. Clin. Microbiol. Infect. 2014, 20, O255–O266. [Google Scholar] [CrossRef]
 - Moldgy, A.; Nayak, G.; Aboubakr, H.A.; Goyal, S.M.; Bruggeman, P.J. Inactivation of virus and bacteria using cold atmospheric pressure air plasmas and the role of reactive nitrogen species. J. Phys. D Appl. Phys. 2020, 53, 434004. [Google Scholar] [CrossRef]
 - Morent, R.; De, N. Inactivation of Bacteria by Non-Thermal Plasmas; InTech eBooks: Houston, TX, USA, 2011; Available online: https://www.intechopen.com/chapters/17641 (accessed on 1 October 2024).
 - Graves, D.B. The emerging role of reactive oxygen and nitrogen species in redox biology and some implications for plasma applications to medicine and biology. J. Phys. D Appl. Phys. 2012, 45, 263001. [Google Scholar] [CrossRef]
 - Polito, J.; Quesada, M.J.H.; Stapelmann, K.; Kushner, M.J. Reaction mechanism for atmospheric pressure plasma treatment of cysteine in solution. J. Phys. D Appl. Phys. 2023, 56, 395205. [Google Scholar] [CrossRef]
 - Eliasson, B.; Hirth, M.; Kogelschatz, U. Ozone synthesis from oxygen in dielectric barrier discharges. J. Phys. D Appl. Phys. 1987, 20, 1421–1437. [Google Scholar] [CrossRef]
 - Pejaković, D.A.; Copeland, R.A.; Cosby, P.C.; Slanger, T.G. Studies on the production of O2(a1Δg, υ = 0) and O2(b1Σg+, υ = 0) from collisional removal of O2(A3Σu+, υ′ = 6–10). J. Geophys. Res. Atmos. 2007, 112, A10307. [Google Scholar] [CrossRef]
 - Fridman, A. Plasma Biology and Plasma Medicine; Cambridge University Press: Cambridge, UK, 2008; pp. 848–914. [Google Scholar] [CrossRef]
 - Blajan, M.; Nonaka, D.; Kristof, J.; Shimizu, K. Study of Induced EHD flow by microplasma vortex Generator. IEEE Trans. Plasma Sci. 2019, 47, 5345–5354. [Google Scholar] [CrossRef]
 - Sakiyama, Y.; Graves, D.B.; Chang, H.-W.; Shimizu, T.; Morfill, G.E. Plasma chemistry model of surface microdischarge in humid air and dynamics of reactive neutral species. J. Phys. D Appl. Phys. 2012, 45, 425201. [Google Scholar] [CrossRef]

| CFU | ||||
|---|---|---|---|---|
| −1.5 kV | −1.7 kV | |||
| Treated | Control | Treated | Control | |
| E. coli | 279 ± 77.7 | 348 ± 44.6 | 222.5 ± 13.4 | 348 ± 44.6 | 
| P. aeruginosa | N.A. | N.A. | N.A. | N.A. | 
| S. aureus | 35.5 ± 6.3 | 205 ± 103.9 | 287 ±69.3 | 205 ± 103.9 | 
| D Values | ||||||
|---|---|---|---|---|---|---|
| −1.5 kV | −1.7 kV | −1.7 kV45 mm Diameter Area | ||||
| Bacterial Liquid Quantity | 50 µL (kJ/50 µL) | 1 mL (kJ/mL) | 50 µL (kJ/50 µL) | 1 mL (kJ/mL) | 50 µL (kJ/50 µL) | 1 mL (kJ/mL) | 
| E. coli | 7.88 | 157.5 | 4.49 | 89.9 | 0.28 | 5.6 | 
| P. aeruginosa | N.A. | N.A. | N.A. | N.A. | N.A. | N.A. | 
| S. aureus | 0.99 | 19.9 | N.A. | N.A. | N.A. | N.A. | 
Disclaimer/Publisher’s Note: The statements, opinions and data contained in all publications are solely those of the individual author(s) and contributor(s) and not of MDPI and/or the editor(s). MDPI and/or the editor(s) disclaim responsibility for any injury to people or property resulting from any ideas, methods, instructions or products referred to in the content.  | 
© 2025 by the authors. Licensee MDPI, Basel, Switzerland. This article is an open access article distributed under the terms and conditions of the Creative Commons Attribution (CC BY) license (https://creativecommons.org/licenses/by/4.0/).
Share and Cite
Blajan, M.G.; Ciorita, A.; Surducan, E.; Surducan, V.; Shimizu, K. Biological Decontamination by Microplasma. Appl. Sci. 2025, 15, 2527. https://doi.org/10.3390/app15052527
Blajan MG, Ciorita A, Surducan E, Surducan V, Shimizu K. Biological Decontamination by Microplasma. Applied Sciences. 2025; 15(5):2527. https://doi.org/10.3390/app15052527
Chicago/Turabian StyleBlajan, Marius Gabriel, Alexandra Ciorita, Emanoil Surducan, Vasile Surducan, and Kazuo Shimizu. 2025. "Biological Decontamination by Microplasma" Applied Sciences 15, no. 5: 2527. https://doi.org/10.3390/app15052527
APA StyleBlajan, M. G., Ciorita, A., Surducan, E., Surducan, V., & Shimizu, K. (2025). Biological Decontamination by Microplasma. Applied Sciences, 15(5), 2527. https://doi.org/10.3390/app15052527
        
